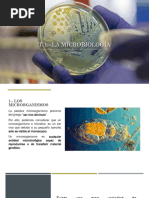
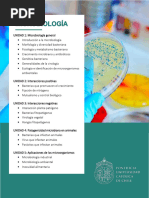

0% encontró este documento útil (0 votos)
31 vistas5 páginasUsos y Aplicaciones de Microorganismos
Este documento trata sobre los microorganismos, sus métodos de estudio, control de crecimiento, importancia en la biosfera y como patógenos. Describe los métodos de aislamiento, tinción, esterilización y fases de infección de los microorganismos así como su participación en ciclos biogeoquímicos.
Cargado por
carlacarofernandez11Derechos de autor
© © All Rights Reserved
Nos tomamos en serio los derechos de los contenidos. Si sospechas que se trata de tu contenido, reclámalo aquí.
Formatos disponibles
Descarga como PDF, TXT o lee en línea desde Scribd
0% encontró este documento útil (0 votos)
31 vistas5 páginasUsos y Aplicaciones de Microorganismos
Este documento trata sobre los microorganismos, sus métodos de estudio, control de crecimiento, importancia en la biosfera y como patógenos. Describe los métodos de aislamiento, tinción, esterilización y fases de infección de los microorganismos así como su participación en ciclos biogeoquímicos.
Cargado por
carlacarofernandez11Derechos de autor
© © All Rights Reserved
Nos tomamos en serio los derechos de los contenidos. Si sospechas que se trata de tu contenido, reclámalo aquí.
Formatos disponibles
Descarga como PDF, TXT o lee en línea desde Scribd